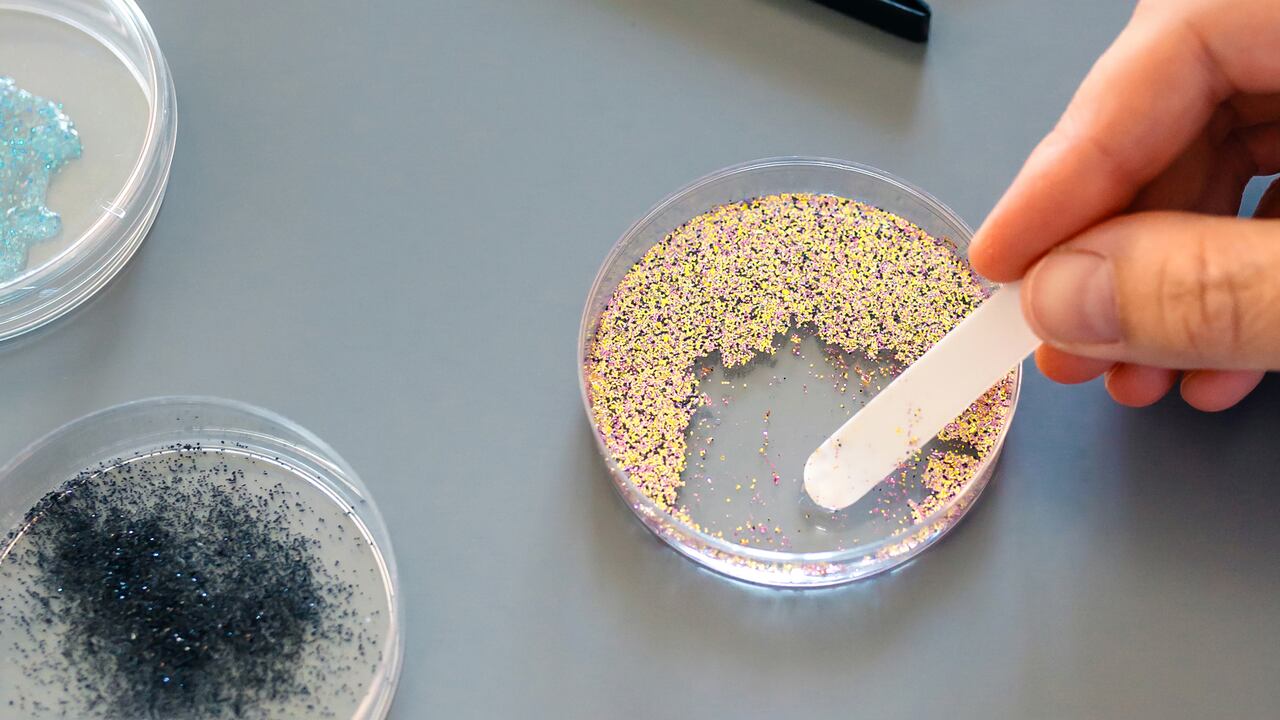
Este reciente estudio demuestra la masiva cantidad de nano y microplásticos que pueden ingresar al cuerpo al masticar chicle.

Un reciente estudio de Queen’s University de Belfast reveló una preocupante alerta debido a que encontraron una alta cantidad de microplásticos en los chicles que suelen masticar de manera frecuentes las personas.
En este análisis, los expertos usaron una técnica llamada “espectroscopia Raman automatizada”, que indica cuántas partículas microscópicas de plástico pueden ingresar a la saliva a través de la masticación de este común dulce. Los resultados indicaron que en una hora se liberan alrededor de 250.000 plásticos.
En la actualidad se tiene conocimiento de que estos elementos entran al cuerpo humano debido a que la mayoría de cosas de uso diario están compuestas de plástico. Sin embargo, aún no estudios que informen sobre los efectos a largo plazo en la salud de los humanos.

“Este estudio contribuye a abordar la contaminación micro y nanoplástica, que es una preocupación mundial, al introducir un método eficaz y accesible para detectar estos plásticos, al tiempo que descubre fuentes de exposición pasadas por alto, como la goma de mascar”, aseguró el doctor Cuong Cao, el autor del estudio.
“Nuestros hallazgos llenan lagunas en la detección de micro y nanoplásticos y subrayan la importancia de generar conciencia y destacar la goma de mascar como una fuente no reconocida de exposición al plástico”, especificó.

Los chicles están compuestos en su mayoría por moléculas largas, conocidas como polímeros. Algunas marcas, usan polímeros naturales, mientras que otras optan por este material sintético que se asemeja al plástico. Además, también se usan otros elementos nocivos para el cuerpo.

“El análisis químico muestra que la goma de mascar contiene estireno-butadieno (el químico sintético duradero utilizado para fabricar neumáticos de automóviles), polietileno (el plástico utilizado para hacer bolsas de transporte y botellas) y acetato de polivinilo (pegamento para madera), así como algunos edulcorantes y saborizantes”, explicó David Jones, profesor de la Universidad de Portsmouth al medio The Conversation.
El estudio, además de analizar los ingredientes de los chicles, también los investigadores propusieron comprender cómo se desarrolla la transferencia de los microplásticos al cuerpo. Para ello, en el análisis participó un voluntario que, luego de lavarse la boca, proporcionó una muestra de saliva inicial.


Posteriormente, se le brindó un chicle para que lo masticara durante una hora, mientras las analistas tomaban pruebas de saliva cada dos minutos. Como resultado, los investigadores notaron que al cabo de una hora, se liberaron 251.244 piezas de microplástico, la mayoría en los primeros 20 minutos del estudio.
“Los microplásticos que se liberan al masticar chicle son relativamente grandes y no sabemos nada sobre los efectos, si los hay, de partículas tan grandes en el cuerpo humano”, afirmaron los científicos de la Universidad de Leiden en un artículo para The Conversation.
Pero, a pesar de la falta de investigaciones sobre los efectos, hasta el momento los expertos aseguran que cada vez hay más pruebas de que la presencia de plástico en el cuerpo puede desarrollar cáncer, al perjudicar las células sanas. Un estudio al respecto a inicios de esta año indicó que las células cancerígenas del intestino se propagan más rápido al contacto con los microplásticos.